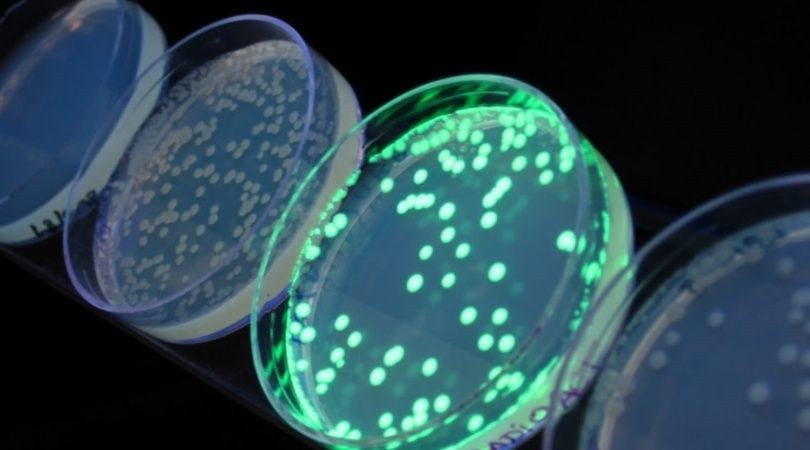
Desarrollan un barbijo que se ilumina en contacto con el coronavirus | Información General

La lucha contra el coronavirus se da en todos los frentes posibles. El mundo científico está volcado a buscar soluciones para el virus.
Ahora, investigadores de la Universidad de Harvard y el Instituto Tecnológico de Massachusetts (MIT) están trabajando para crear una máscara facial que pueda detectar si la persona que la usa tiene el coronavirus.
En estos momentos, están ajustando los sensores que comenzaron a desarrollar en el 2014 para detectar el virus del ébola con el objetivo de que contribuya ahora a abordar la pandemia del covid-19, dijo el investigador del MIT Jim Collins a Business Insider.
Los científicos del MIT y de Harvard publicaron su investigación sobre el dispositivo en el 2016, después de adaptar la tecnología para abordar el virus del zika.
La máscara que los investigadores están desarrollando produce una señal fluorescente cuando una persona con el coronavirus respira, tose o estornuda, según publica Business Insider.
MIRÁ TAMBIÉN
Otro coronavirus hallado en murciélagos demuestra que el covid-19 no se generó en un laboratorio
Cavan miles de tumbas en Chile por el avance del coronavirus









